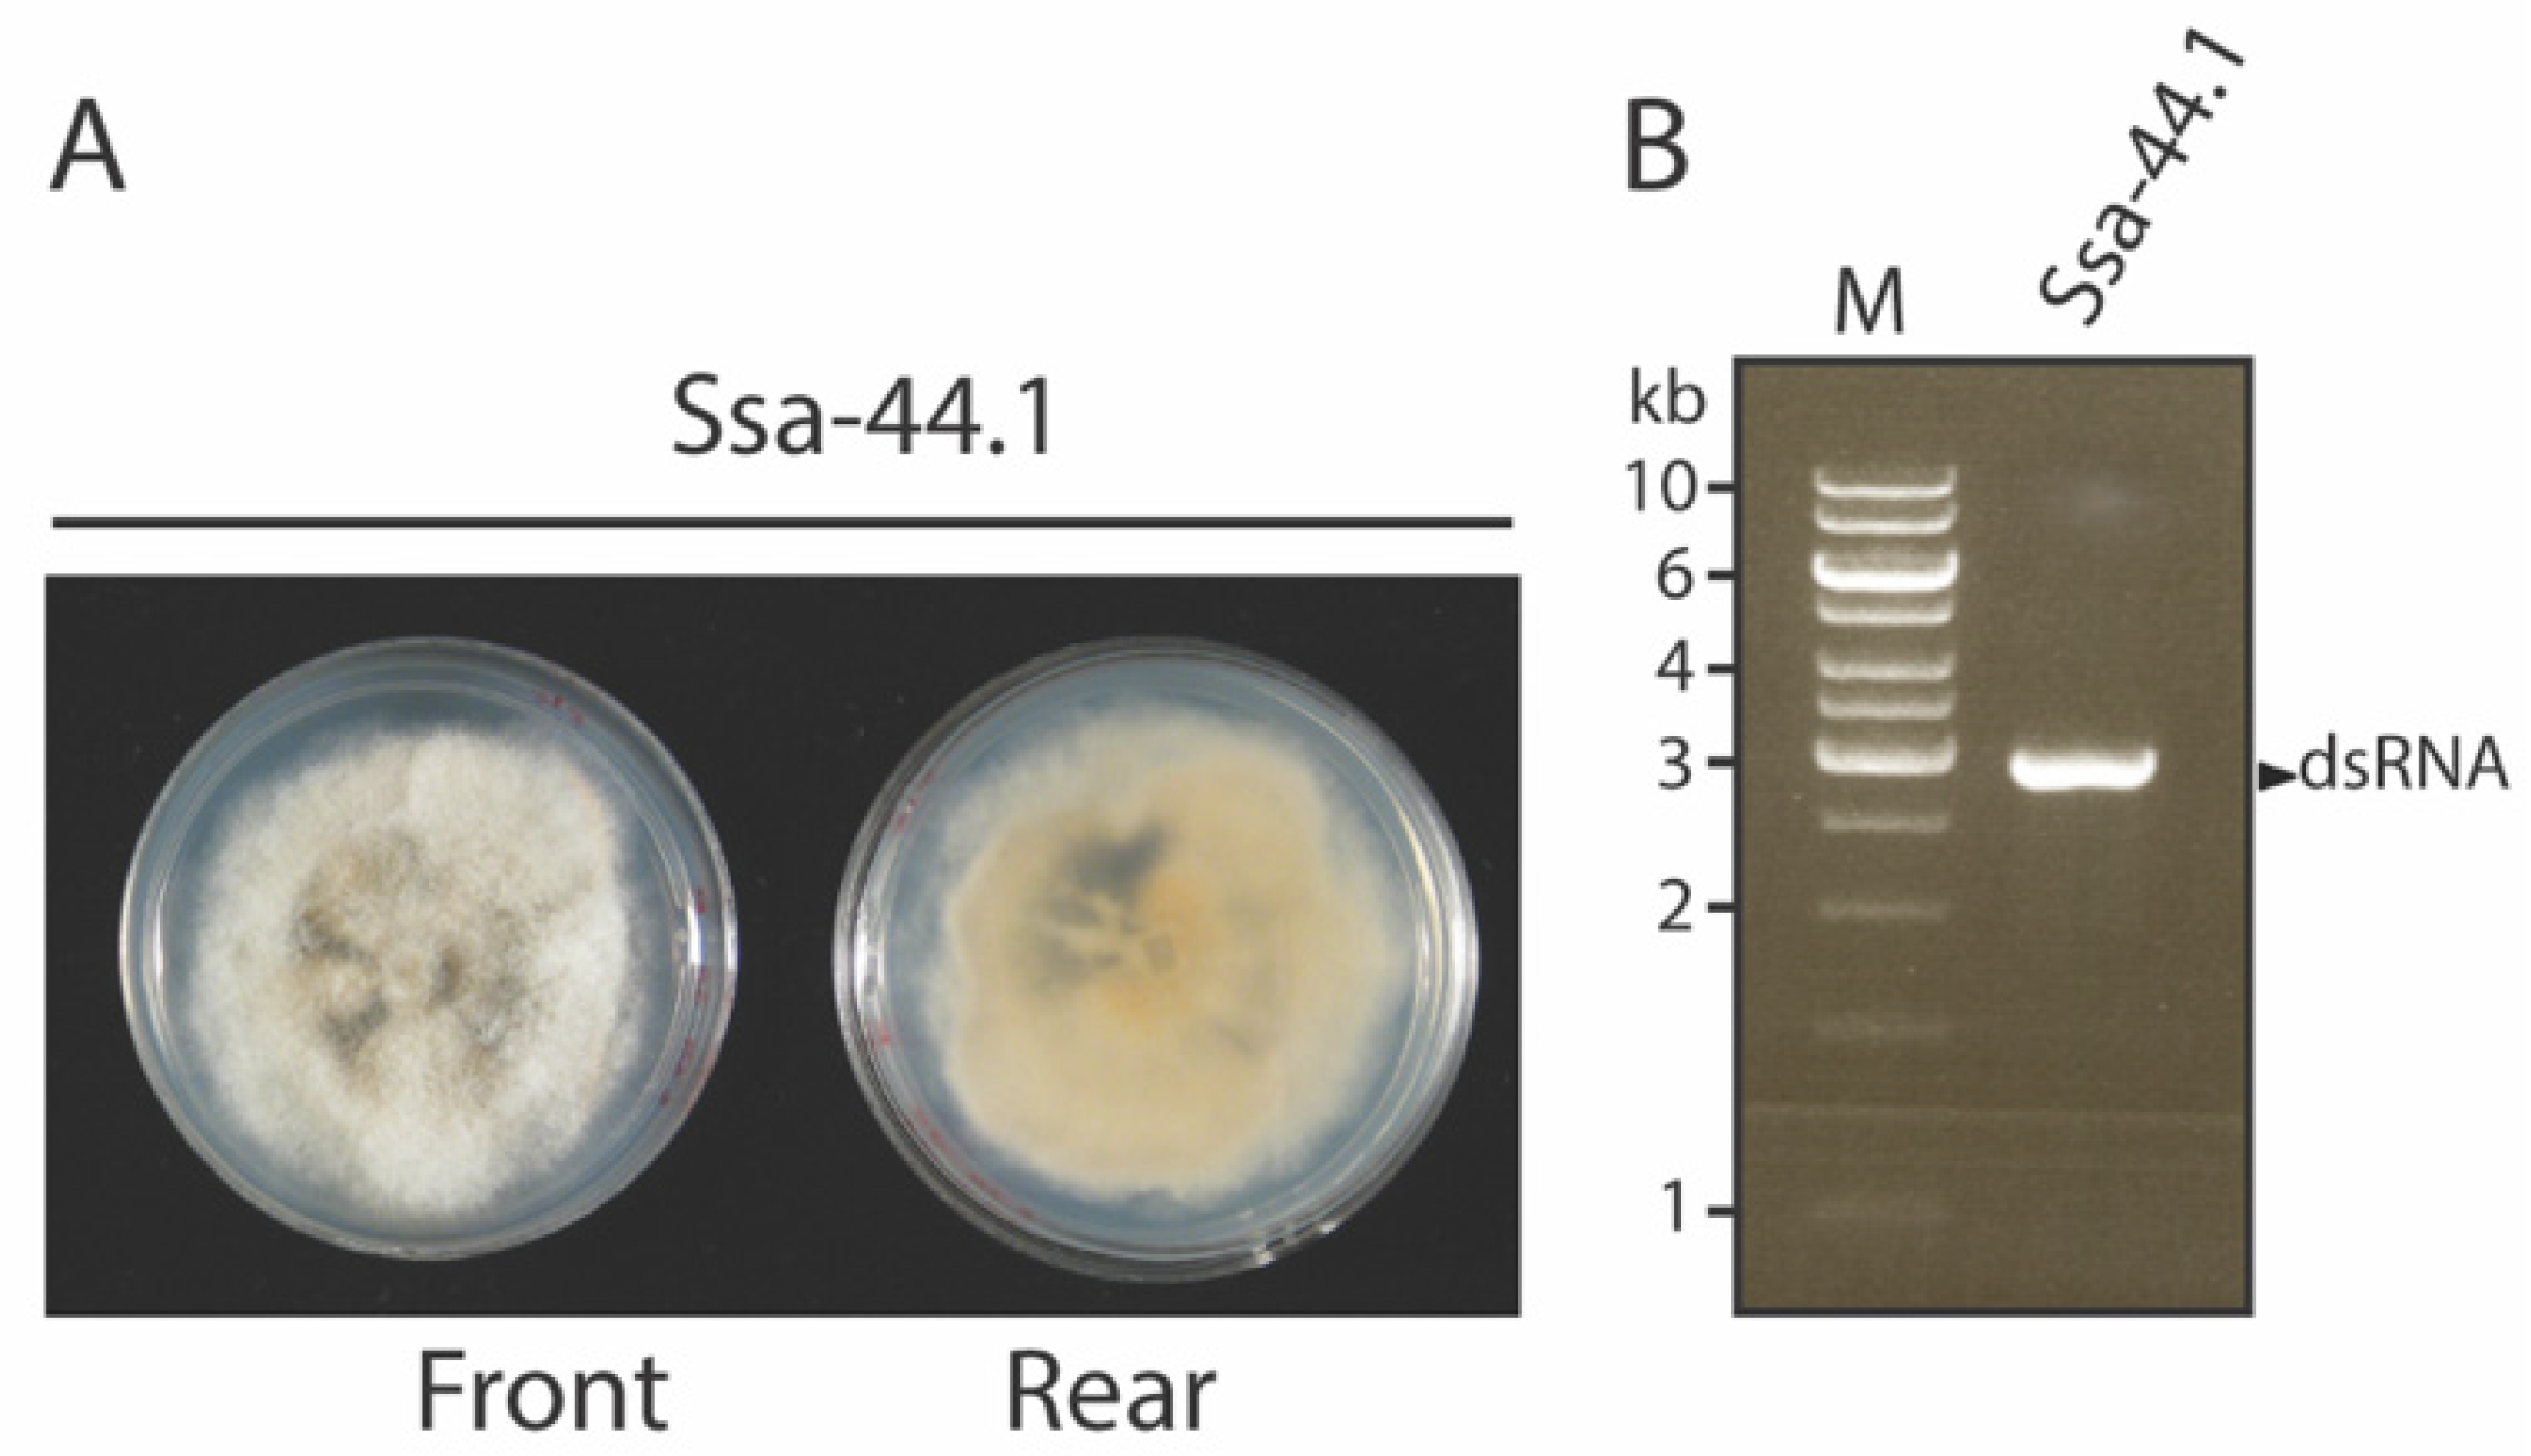
Viruses 14 01921 g001 Viruses 14 01921 g001
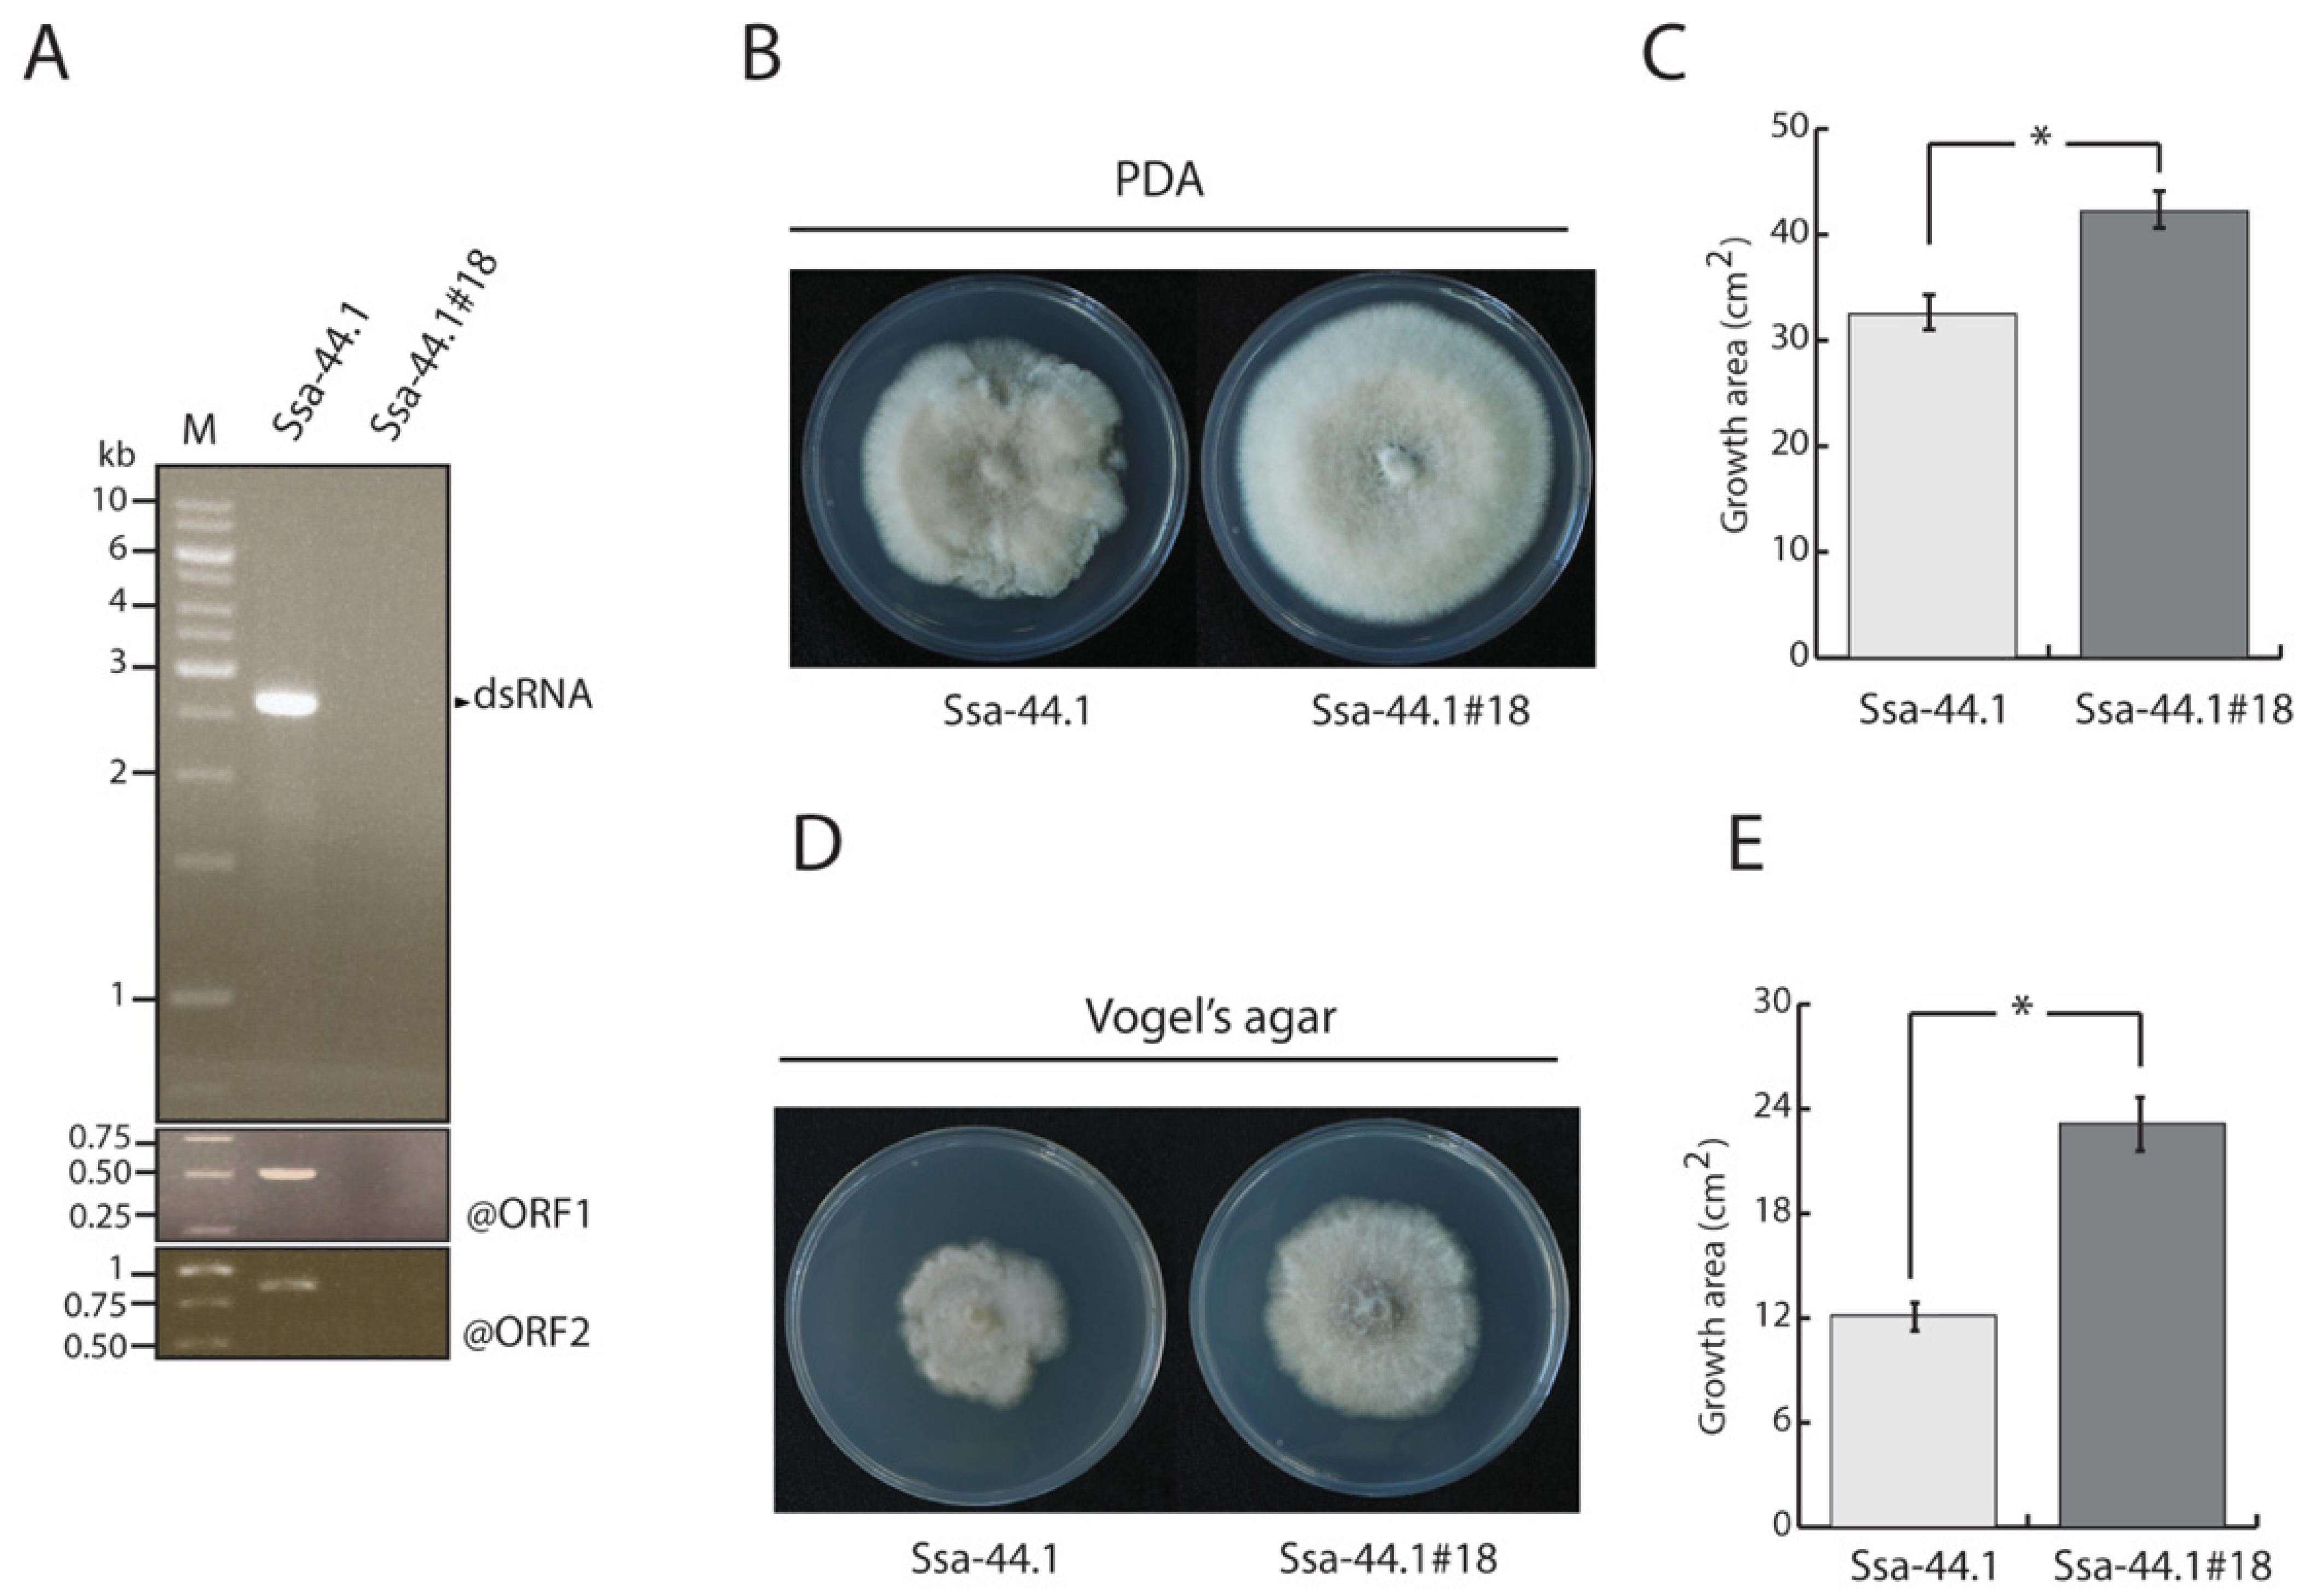
Viruses 14 01921 g003 Viruses 14 01921 g003
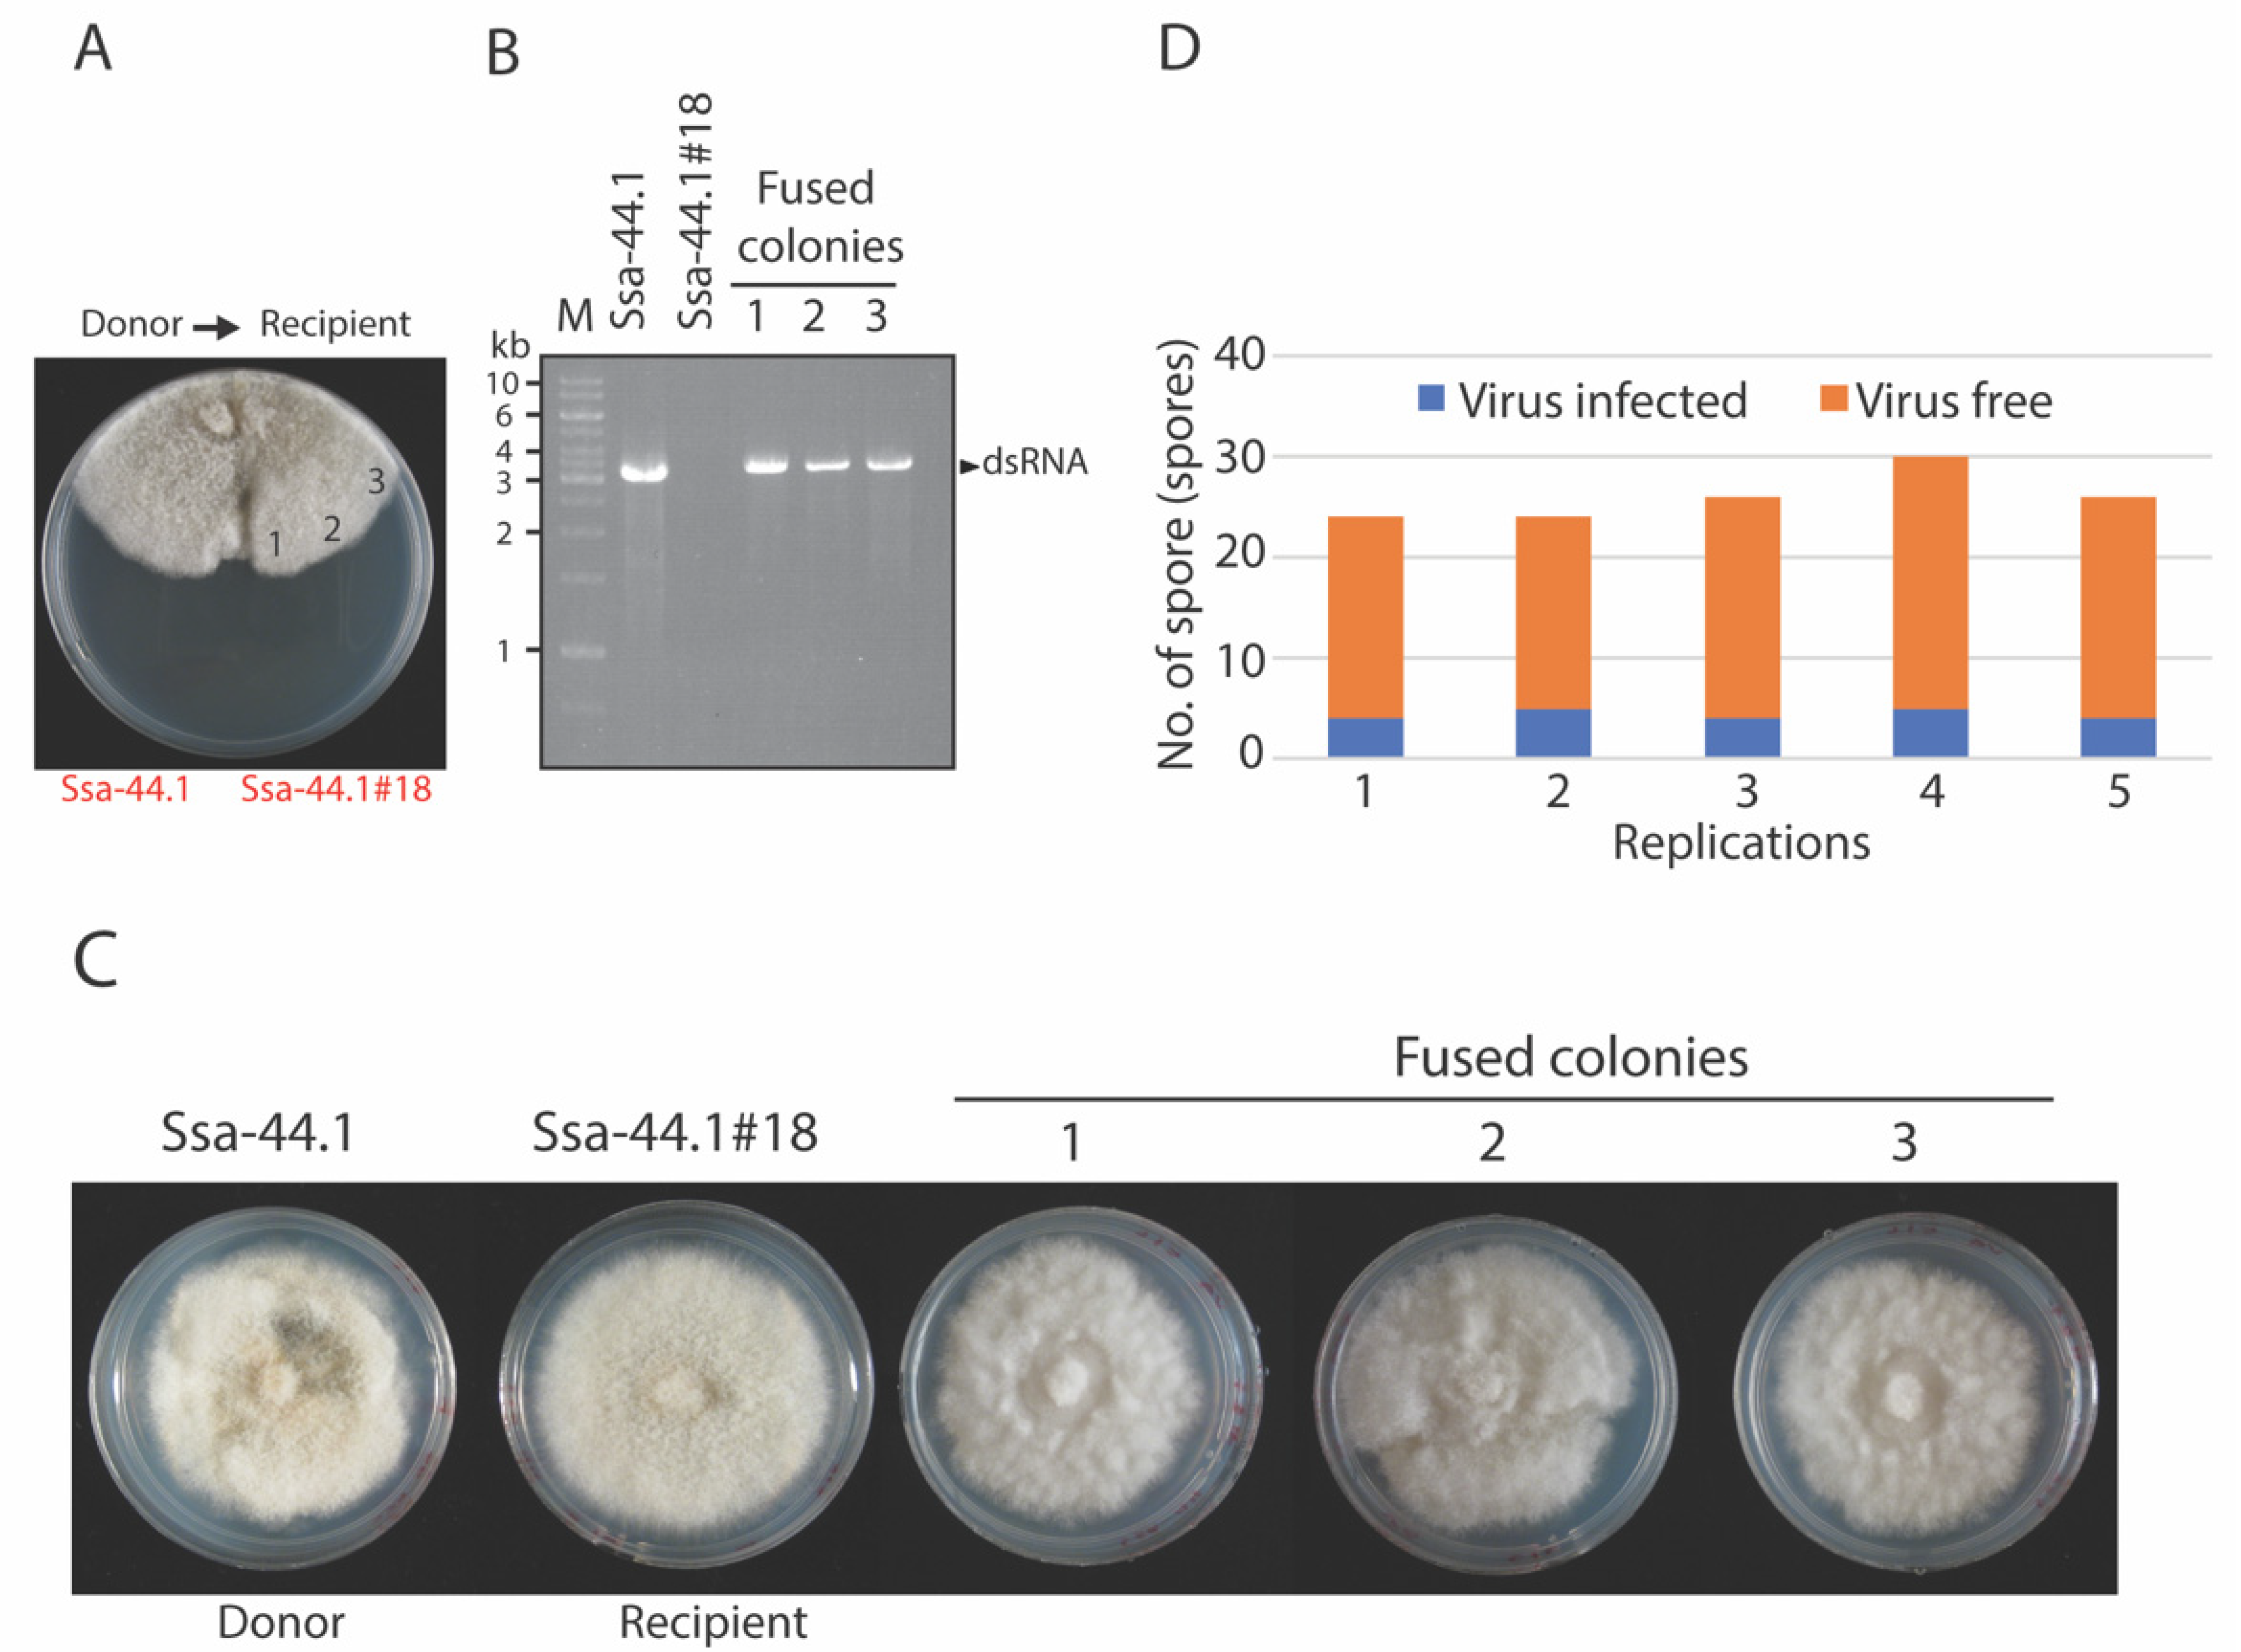
Viruses 14 01921 g004 Viruses 14 01921 g004

Hypovirulence of Colletotrichum gloesporioides Associated with dsRNA Mycovirus Isolated from a Mango Orchard in Thailand
Abstract
1. Introduction
2. Materials and Methods
2.1. Fungal Isolates, Growth Conditions, and Taxonomic Analysis
2.2. Extraction of dsRNA from Fungal Mycelium
2.3. Full-Length Analysis by Next-Generation Sequencing (NGS) Approach and RACE
2.4. Bioinformatic and Phylogenetic Analysis
2.5. Elimination of C. gloeosporioides Strain Ssa-44.1 dsRNA
2.6. Virus Transmission
Horizontal Transmission
2.7. Effect of Mycovirus on Fungal Colony Morphology, Growth, and Pathogenicity
2.8. Statistical Analyses
3. Results
3.1. Identification and Biological Characteristic of Virus-Infected Isolate Ssa-44.1
3.2. Genome Organization and Phylogenetic Analysis of Mycovirus Ssa-44.1
3.3. Biological Properties of CgRV1-Ssa-44.1 on C. gloeosporioides
3.4. Transmission of CgRV1-Ssa-44.1 in C. gloeosporioides
3.5. Effect of CgRV1-Ssa-44.1 on Virulence of C. gloeosporioides
4. Discussion
Supplementary Materials
Author Contributions
Funding
Institutional Review Board Statement
Informed Consent Statement
Data Availability Statement
Acknowledgments
Conflicts of Interest
References
- Arauz, L.F. Mango Anthracnose: Economic Impact and Current Options for Integrated Management. Plant Dis. 2000, 84, 600–611. [Google Scholar] [CrossRef] [PubMed]
- Cannon, P.F.; Damm, U.; Johnston, P.R.; Weir, B.S. Colletotrichum—Current status and future directions. Stud. Mycol. 2012, 73, 181–213. [Google Scholar] [CrossRef] [PubMed]
- Gautam, A.K. The Genera Colletotrichum: An Incitant of Numerous New Plant Diseases in India. J. New Biol. Rep. 2014, 3, 9–21. [Google Scholar]
- Food and Agriculture Organization of the United Nations. Major Tropical Fruits: Preliminary Results 2020. Available online: http://www.fao.org/economic/est/est-commodities/tropical-fruits/en/ (accessed on 25 May 2022).
- Paull, R.E.; Duarte, O. Tropical Fruits, 2nd ed.; CABI Publishing: London, UK, 2011; Volume 1, pp. 252–290. [Google Scholar]
- Weir, B.S.; Johnston, P.R.; Damm, U. The Colletotrichum gloeosporioides Species Complex. Stud. Mycol. 2012, 73, 115–180. [Google Scholar] [CrossRef]
- Vidyalakshni, A.; Divya, C.V. New report of Colletotrichum gloeosporioides causing anthracnose of Pisonia alba in India. Arch. Phytopathol. Plant. Prot. 2013, 46, 201–204. [Google Scholar] [CrossRef]
- da Silva, L.L.; Moreno, H.L.A.; Correia, H.L.N.; Santana, M.F.; de Queiroz, M.V. Colletotrichum: Species Complexes, Lifestyle and Peculiarities of Some Sources of Genetic Variability. Appl. Microbiol. Biotechnol. 2020, 104, 1891–1904. [Google Scholar] [CrossRef]
- Yakoby, N.; Beno-Moualem, D.; Keen, N.T.; Dinoor, A.; Pines, O.; Prusky, D. Colletotrichum gloeosporioides PelB Is an Important Virulence Factor in Avocado Fruit-Fungus Interaction. Mol. Plant Microbe Interact. 2001, 14, 988–995. [Google Scholar] [CrossRef]
- Chudasama, K.S.; Monpara, J.K.; Thaker, V.S. Identification and Characterization of Pectin Lyase Gene as a Virulence Factor in Colletotrichum gloeosporioides. Physiol. Mol. Plant. Pathol. 2021, 116, 101706. [Google Scholar] [CrossRef]
- Liang, C.; Zhang, B.; Zhou, Y.; Yin, H.; An, B.; Lin, D.; He, C.; Luo, H. CgNPG1 as a Novel Pathogenic Gene of Colletotrichum Gloeosporioides from Hevea Brasiliensis in Mycelial Growth, Conidiation and the Invasive Structures Development. Front. Microbiol. 2021, 12, 629387. [Google Scholar] [CrossRef]
- Jakhar, M.S.; Pathak, S. Effect of Pre-harvest Nutrients Application and Bagging on Quality and Shelf Life of Mango (Mangifera indica L.). J. Agric. Sci. Technol. 2016, 18, 717–729. [Google Scholar]
- Jamalizadeh, M.; Etebarian, H.R.; Aminia, H.; Alizadeh, A. A review of mechanisms of action of biological control organisms against post-harvest fruit spoilage. Bull. OEPP 2011, 41, 65–71. [Google Scholar] [CrossRef]
- Droby, S.; Wisniewski, M.; Macarisin, D.; Wilson, C. Twenty years of postharvest biocontrol research: Is it time for a new paradigm? Postharvest Biol. Technol. 2009, 5, 137–145. [Google Scholar] [CrossRef]
- Tariq, M.; Khan, A.; Asif, M.; Khan, F.; Ansari, T.; Shariq, M.; Siddiqui, M.A. Biological control: A sustainable and practical approach for plant disease management, Acta Agric. Scand. B Soil Plant Sci. 2020, 70, 507–524. [Google Scholar] [CrossRef]
- Anagnostakis, S.L. Biological Control of Chestnut Blight. Science 1982, 215, 466–471. [Google Scholar] [CrossRef]
- Heiniger, U.; Rigling, D. Biological control of chestnut blight in Europe. Annu. Rev. Phytopathol. 1994, 32, 581–599. [Google Scholar] [CrossRef]
- Chiba, S.; Salaipeth, L.; Lin, Y.S.; Sasaki, A.; Kanematsu, S.; Suzuki, N. A Novel Bipartite Double-Stranded RNA Mycovirus from the White Root Rot Fungus Rosellinia necatrix: Molecular and Biological Characterization, Taxonomic Considerations and Potential for Biological Control. J. Virol. 2009, 83, 12801–12812. [Google Scholar] [CrossRef]
- Yu, X.; Li, B.; Fu, Y.; Xie, J.; Cheng, J.; Ghabrial, S.A.; Li, G.; Yi, X.; Jiang, D. Extracellular transmission of a DNA mycovirus and its use as a natural fungicide. Proc. Natl. Acad. Sci. USA 2013, 110, 1452–1457. [Google Scholar] [CrossRef]
- Wang, X.; Lai, J.; Hu, H.; Yang, J.; Zang, K.; Zhao, F.; Zeng, G.; Liao, Q.; Gu, Z.; Du, Z. Infection of Nigrospora nonsegmented RNA Virus 1 Has Important Biological Impacts on a Fungal Host. Viruses 2022, 14, 795. [Google Scholar] [CrossRef]
- Kotta-Loizou, I.; Coutts, R.H.A. Mycoviruses in Aspergilli: A Comprehensive Review. Front. Microbiol. 2017, 8, 1699. [Google Scholar] [CrossRef]
- Ghabrial, S.A.; Suzuki, N. Viruses of plant pathogenic fungi. Annu. Rev. Phytopathol. 2009, 47, 353–384. [Google Scholar] [CrossRef]
- Lemus-Minor, C.G.; Cañizares, M.C.; García-Pedrajas, M.D.; Pérez-Artés, E. Horizontal and Vertical Transmission of the Hypovirulence-Associated Mycovirus Fusarium Oxysporum f. Sp. Dianthi Virus 1. Eur. J. Plant Pathol. 2019, 153, 645–650. [Google Scholar] [CrossRef]
- Pearson, M.N.; Beever, R.E.; Boine, B.; Arthur, K. Mycoviruses of Filamentous Fungi and Their Relevance to Plant Pathology. Mol. Plant. Pathol. 2009, 10, 115–128. [Google Scholar] [CrossRef] [PubMed]
- Figueirêdo, L.C.; Figueirêdo, G.S.; Giancoli, Á.C.H.; Tanaka, F.A.O.; Silva, L.A.O.; Kitajima, E.W.; Filho, S.A.; Azevedo, J.L. Detection of isometric, dsRNA-containing viral particles in Colletotrichum gloeosporioides isolated from cashew tree. Trop. Plant Pathol. 2012, 37, 142–145. [Google Scholar] [CrossRef]
- Zhong, J.; Pang, X.D.; Zhu, H.J.; Gao, B.D.; Huang, W.K.; Zhou, Q. Molecular Characterization of a Trisegmented Mycovirus from the Plant Pathogenic Fungus Colletotrichum gloeosporioides. Viruses 2016, 8, 268. [Google Scholar] [CrossRef] [PubMed]
- Guo, J.; Zhu, J.Z.; Zhou, X.Y.; Zhong, J.; Li, C.H.; Zhang, Z.G.; Zhu, H.J. A novel ourmia-like mycovirus isolated from the plant pathogenic fungus Colletotrichum gloeosporioides. Arch. Virol. 2019, 164, 2631–2635. [Google Scholar] [CrossRef] [PubMed]
- Wang, Y.; Liu, S.; Zhu, H.J.; Zhong, J. Molecular characterization of a novel mycovirus from the plant pathogenic fungus Colletotrichum gloeosporioides. Arch. Virol. 2019, 164, 2859–2863. [Google Scholar] [CrossRef] [PubMed]
- Balijja, A.; Kvarnheden, A.; Turchetti, T. A non-phenol–chloroform extraction of double-stranded RNA from plant and fungal tissues. J. Virol. Methods 2008, 152, 32–37. [Google Scholar] [CrossRef]
- Chiba, S.; Lin, Y.H.; Kondo, H.; Kanematsu, S.; Suzuki, N. Effects of defective interfering RNA on symptom induction by and replication of, a novel partitivirus from a phytopathogenic fungus, Rosellinia necatrix. J. Virol. 2013, 87, 2330–2341. [Google Scholar] [CrossRef]
- Eusebio-Cope, A.; Sun, L.; Hillman, B.I.; Suzuki, N. Mycoreovirus 1 S4-coded protein is dispensable for viral replication but necessary for efficient vertical transmission and normal symptom induction. Virology 2010, 397, 399–408. [Google Scholar] [CrossRef]
- Vogel, H.J. A Convenient Growth Medium for Neurospora crassa. Microbiol. Genet. Bull. 1956, 13, 42–47. [Google Scholar]
- Yang, S.; Dai, R.; Salaipeth, L.; Huang, L.; Liu, J.; Andika, I.B.; Sun, L. Infection of Two Heterologous Mycoviruses Reduces the Virulence of Valsa mali, a Fungal Agent of Apple Valsa Canker Disease. Front. Microbiol. 2021, 12, 659210. [Google Scholar] [PubMed]
- Gilbert, K.B.; Holcomb, E.E.; Allscheid, R.L.; Carrington, J.C. Hiding in plain sight: New virus genomes discovered via a systematic analysis of fungal public transcriptomes. PLoS ONE 2019, 14, e0219207. [Google Scholar]
- Nerva, L.; Ciuffo, M.; Vallino, M.; Margaria, P.; Varese, G.C.; Gnavi, G.; Turina, M. Multiple approaches for the detection and characterization of viral and plasmid symbionts from a collection of marine fungi. Virus Res. 2016, 219, 22–38. [Google Scholar] [PubMed]
- Campo, S.; Gilbert, K.B.; Carrington, J.C. Small RNA-Based Antiviral Defense in the Phytopathogenic Fungus Colletotrichum higginsianum. PLoS Pathog. 2016, 12, e1005640. [Google Scholar]
- Jiang, Y.; Zhang, T.; Luo, C.; Jiang, D.; Li, G.; Li, Q.; Hsiang, T.; Huang, J. Prevalence and diversity of mycoviruses infecting the plant pathogen Ustilaginoidea virens. Virus Res. 2015, 195, 47–56. [Google Scholar]
- Zhang, L.; Yan, C.; Guo, Q.; Zhang, J.; Ruiz-Menjivar, J. The impact of agricultural chemical inputs on environment: Global evidence from informetrics analysis and visualization. Int. J. Low Carbon Technol. 2018, 13, 338–352. [Google Scholar] [CrossRef]
- Neang, S.; Bincader, S.; Rangsuwan, S.; Keawmanee, P.; Rin, S.; Salaipeth, L.; Das, S.; Kondo, H.; Suzuki, N.; Sato, I.; et al. Omnipresence of Partitiviruses in Rice Aggregate Sheath Spot Symptom-Associated Fungal Isolates from Paddies in Thailand. Viruses 2021, 13, 2269. [Google Scholar] [CrossRef]
- van Diepeningen, A.D.; Debets, A.J.; Hoekstra, R.F. Dynamics of dsRNA mycoviruses in black Aspergillus populations. Fungal Genet. Biol. 2006, 43, 446–452. [Google Scholar] [CrossRef]
- Chu, Y.M.; Lim, W.S.; Yea, S.J.; Cho, J.D.; Lee, Y.W.; Kim, K.H. Complexity of dsRNA mycovirus isolated from Fusarium graminearum. Virus Genes 2004, 28, 135–143. [Google Scholar] [CrossRef]
- Nuss, D. Hypovirulence: Mycoviruses at the fungal–plant interface. Nat. Rev. Microbiol. 2005, 3, 632–642. [Google Scholar] [CrossRef]
- Shafik, K.; Umer, M.; You, H.; Aboushedida, H.; Wang, Z.; Ni, D.; Xu, W. Characterization of a Novel Mitovirus Infecting Melanconiella theae Isolated from Tea Plants. Front. Microbiol. 2021, 12, 757556. [Google Scholar] [CrossRef]
- Wang, M.; Wang, Y.; Sun, X.; Cheng, J.; Fu, Y.; Liu, H.; Jiang, D.; Ghabrial, S.A.; Xie, J. Characterization of a Novel Megabirnavirus from Sclerotinia sclerotiorum Reveals Horizontal Gene Transfer from Single-Stranded RNA Virus to Double-Stranded RNA Virus. J. Virol. 2015, 89, 8567–8579. [Google Scholar] [CrossRef]
- Zhao, Y.; Zhang, Y.; Wan, X.; She, Y.; Li, M.; Xi, H.; Xie, J.; Wen, C. A Novel Ourmia-Like Mycovirus Confers Hypovirulence-Associated Traits on Fusarium oxysporum. Front. Microbiol. 2020, 11, 569869. [Google Scholar] [CrossRef] [PubMed]
- Glass, N.L.; Jacobson, D.J.; Shiu, P.K. The Genetics of Hyphal Fusion and Vegetative Incompatibility in Filamentous Ascomycete Fungi. Annu. Rev. Genet. 2000, 34, 165–186. [Google Scholar] [CrossRef] [PubMed]
- Garnjobst, L.; Wilson, J.F. Heterocaryosis and Protoplasmic Incompability in Neurospora Crassa. Proc. Natl. Acad. Sci. USA 1956, 42, 613–618. [Google Scholar] [CrossRef] [PubMed]
- Lee, K.M.; Cho, W.K.; Yu, J.; Son, M.; Choi, H.; Min, K. A comparison of transcriptional patterns and mycological phenotypes following infection of Fusarium graminearum by four mycoviruses. PLoS ONE 2014, 9, e100989. [Google Scholar] [CrossRef]
- Suzuki, N.; Maruyama, K.; Moriyama, M.; Nuss, D.L. Hypovirus papain-like protease p29 functions in trans to enhance viral double-stranded RNA accumulation and vertical transmission. J. Virol. 2003, 77, 11697–11707. [Google Scholar] [CrossRef][Green Version]
- Jia, H.; Dong, K.; Zhou, L.; Wang, G.; Hong, N.; Jiang, D.; Xu, W. A dsRNA virus with filamentous viral particles. Nat. Commun. 2017, 8, 168. [Google Scholar] [CrossRef]
- Zhou, L.; Li, X.; Kotta-Loizou, I.; Dong, K.; Li, S.; Ni, D.; Hong, N.; Wang, G.; Xu, W. A mycovirus modulates the endophytic and pathogenic traits of a plant associated fungus. ISME J. 2021, 15, 1893–1906. [Google Scholar] [CrossRef]

| Strains | Spore Counting (Spores/mL) | |||
|---|---|---|---|---|
| 1 | 2 | 3 | Mean ± SD * | |
| Ssa-44.1 | 2.58 × 107 | 1.85 × 107 | 2.38 × 107 | 2.27 ± 0.38 × 107 a |
| Ssa-44.1#18 | 4.25 × 108 | 5.39 × 108 | 4.95 × 108 | 4.86 ± 0.57 × 108 b |
Publisher’s Note: MDPI stays neutral with regard to jurisdictional claims in published maps and institutional affiliations. |
© 2022 by the authors. Licensee MDPI, Basel, Switzerland. This article is an open access article distributed under the terms and conditions of the Creative Commons Attribution (CC BY) license (https://creativecommons.org/licenses/by/4.0/).
Share and Cite
Suharto, A.R.; Jirakkakul, J.; Eusebio-Cope, A.; Salaipeth, L. Hypovirulence of Colletotrichum gloesporioides Associated with dsRNA Mycovirus Isolated from a Mango Orchard in Thailand. Viruses 2022, 14, 1921. https://doi.org/10.3390/v14091921
Suharto AR, Jirakkakul J, Eusebio-Cope A, Salaipeth L. Hypovirulence of Colletotrichum gloesporioides Associated with dsRNA Mycovirus Isolated from a Mango Orchard in Thailand. Viruses. 2022; 14(9):1921. https://doi.org/10.3390/v14091921
Chicago/Turabian StyleSuharto, Aditya R., Jiraporn Jirakkakul, Ana Eusebio-Cope, and Lakha Salaipeth. 2022. "Hypovirulence of Colletotrichum gloesporioides Associated with dsRNA Mycovirus Isolated from a Mango Orchard in Thailand" Viruses 14, no. 9: 1921. https://doi.org/10.3390/v14091921
APA StyleSuharto, A. R., Jirakkakul, J., Eusebio-Cope, A., & Salaipeth, L. (2022). Hypovirulence of Colletotrichum gloesporioides Associated with dsRNA Mycovirus Isolated from a Mango Orchard in Thailand. Viruses, 14(9), 1921. https://doi.org/10.3390/v14091921

